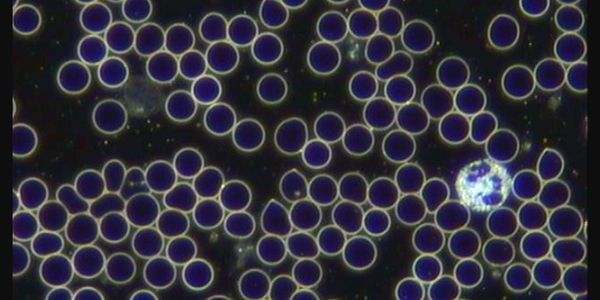

Wellness Coaching - Holistic Nutrition
About Us
Holistic Health Approach
Supporting the Body for Optimal Health
Holistic Wellness Coaching
Our Milwaukee- based holistic wellness coaching services focus on integrating mind, body, and spirit for optimal health. We provide personalized plans that address your unique goals and lifestyle.
Learn natural and accessible ways feeling more like yourself again.
Empower yourself with sustainable habits for long-term vitality.
Live Cell Microscopy (LCM)
On occasion, a special microscope may be used to review
a drop of blood or saliva. This cutting-edge process, known as live cell microscopy, provides a unique perspective on your health.
A live cell review is a noninvasive way for you to learn,
feel empowered, and track your progress.
This is your healing journey.
We are here to support, educate, and encourage you toward wellness.
*Live cell microscopy is not substitute for medical lab work and is not used for diagnosis, treat, or cure disease - for educational purposes only.
This website uses cookies.
We use cookies to analyze website traffic and optimize your website experience. By accepting our use of cookies, your data will be aggregated with all other user data.
-28f94a7.jpg/:/rs=h:104,cg:true,m/qt=q:95)
